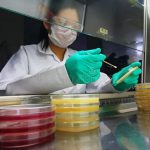

Welcome To
Office of Institutional Biosafety Committee
The Institutional Biosafety Committee (IBC) at Dow University of Health Sciences was established in 2020 to ensure the safe and ethical conduct of research involving biological materials. By facilitating educational initiatives and providing resources, the IBC enhances researchers', faculty members, students and staff members' understanding of biosafety principles, ensuring that innovative research is conducted with the utmost consideration for ethical standards and regulatory requirements. The aim of the committee is to encourage laboratory practices that safeguard human health and the environment.
Our
Scope
The DUHS-IBC shall ensure that research, diagnostic and clinical work in DUHS and its constituents and affiliated institutes is performed in a safe, risk-free environment. It provides guidance in cases of breach of safety and advises corrective action when such happens. The scope of DUHS-IBC may be extended as deemed necessary after formal approval from the aforementioned bodies.
Functions
The IBC performs and oversees various activities, including but not limited to:
- Review of research proposals involving potentially biohazardous materials and chemicals
- Review research involving Living Modified Organisms (LMOs)/rDNA Materials
- Review research involving diagnostic/research procedures on human samples
- Providing guidance to researchers on biohazard control and best practices
- Representing public health and environmental interests in research activities
- Ensuring adherence to biosafety regulations and institutional policies
- Evaluating the adequacy of research facilities and safety protocols
- Ensuring proper training for Principal Investigators and laboratory personnel
- Assessing and recommending appropriate containment levels for research activities
- Monitoring research for potential dual-use concerns

Our Team
Latest News
Organizing a Walk & Seminar on the occasion of “WORLD ALLERGY WEEK 2026”
3rd Orthopaedic Surgery FCPS-II TOACS Preparatory Course
(Provisional) Seniority Lists of Regular Employees Working in (BPS-01 to BPS-15)
Training Session “Elevating Hospital Experience: Training for Frontline Personnel”
(Register Today) Online Session on Ethical Principles in Laboratory Animal Science for Translational Research
Active Learning in Action: A Practical Guide to PBL for Dental Faculty
(Apply Today) DATE EXTENDED: Apply by June 14 for FREE Govt-Certified AI & Digital Courses at DSDC!
Contact Us
OFFICE OF INSTITUTIONAL BIOSAFETY COMMITTEE (IBC)
Call
E-mail:
Address
Serobiology Building 1st Floor, DDRRL, DUHS